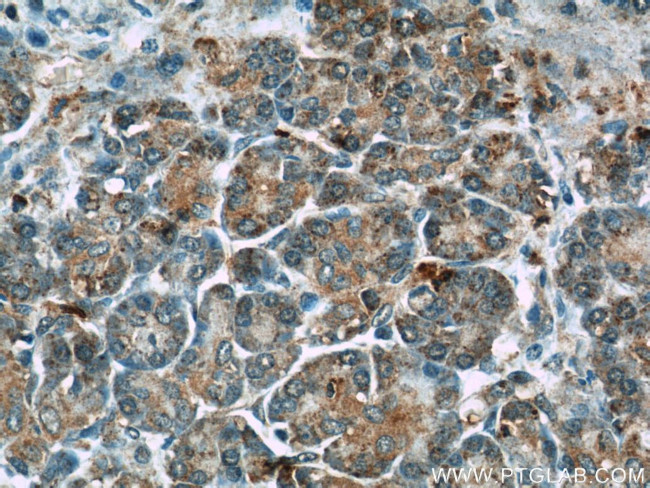
THADA Antibody in Immunohistochemistry (Paraffin) (IHC (P))

Search
Proteintech
THADA Polyclonal Antibody
{{$productOrderCtrl.translations['antibody.pdp.commerceCard.promotion.promotions']}}
{{$productOrderCtrl.translations['antibody.pdp.commerceCard.promotion.viewpromo']}}
{{$productOrderCtrl.translations['antibody.pdp.commerceCard.promotion.promocode']}}: {{promo.promoCode}} {{promo.promoTitle}} {{promo.promoDescription}}. {{$productOrderCtrl.translations['antibody.pdp.commerceCard.promotion.learnmore']}}
产品信息
12909-1-AP
种属反应
已发表种属
宿主/亚型
分类
类型
抗原
偶联物
形式
浓度
规格
纯化类型
保存液
内含物
保存条件
运输条件
产品详细信息
Immunogen sequence: TSSALSMGP FVPFIMRCGH SPVYHSREMA ARALVPFVMI DHIPNTIRSL LSTLPSCTDQ CFRQNHIHGT LLQVFHLLQA YSDSKHGTNS DFQHELTDIT VCTKAKLWLA KRQNPCLVTR AVYIDILFLL TCCLNRSAKD NQPVLESLGF WEEVRGIISG SELITGFPWA FKVPGLPQYL QSLTRLAIAA VWAAAAKSGE RETNVPISFS QLLESAFPEV RSLTLEALLE KFLAAASGLG EKGVPPLLCN MGEKFLLLAM KENHPECFCK ILKILHCMDP GEWLPQTEHC VHLTPKEFLI WTMDIASNER SEIQSVALRL ASKVISHHMQ TCVENRELIA AEL (59-400 aa encoded by BC025773)
靶标信息
THADA (thyroid adenoma associated), also known as GITA, is a 1,953 amino acid protein that is expressed in testis, thyroid, pancreas, stomach and small intestine. Chromosomal aberrations in the gene encoding THADA are associated with benign thyroid adenomas, suggesting a potential role for THADA in tumorigenesis. The THADA gene maps to human chromosome 2, which houses over 1,400 genes and comprises nearly 8% of the human genome. Harlequin icthyosis, a rare and morbid skin deformity, is associated with mutations in the chromosome 2-localized ABCA12 gene, while the lipid metabolic disorder sitosterolemia is associated with defects in the ABCG5 and ABCG8 genes, which also map to chromosome 2.
仅用于科研。不用于诊断过程。未经明确授权不得转售。
生物信息学
蛋白别名: death receptor-interacting protein; Gene inducing thyroid adenomas protein; GITA; GITA-A2; Thyroid adenoma-associated protein; Thyroid adenoma-associated protein homolog; Trm732 homolog; tRNA (32-2'-O)-methyltransferase regulator THADA; unnamed protein product
基因别名: 6530405K19; A930021O22; ARMC13; AU019899; BC052885; GITA; KIAA1767; RGD1560519; THADA; Trm732
UniProt ID: (Human) Q6YHU6, (Mouse) A8C756
Entrez Gene ID: (Human) 63892, (Rat) 313865, (Mouse) 240174